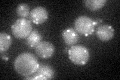
YGR239C
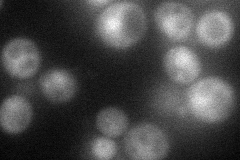
YGR239C
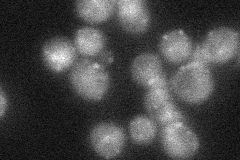
YGR239C
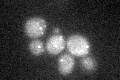
YGR239C

View description
Peroxin required for targeting of peroxisomal matrix proteins containing PTS2; interacts with Pex7p; partially redundant with Pex18p
Localization:
Intensity:
Fold change:
Significance:
-
C’ GFP library in SD
punctate29.04 -
N' NOP1pr-GFP in SD
cytosol,nucleus46.5601 -
N' TEF2pr-mCherry in SD

cytosol22.3292 -
N' NATIVEpr-GFP in SD
punctate32.8469 -
N' TEF2pr-VC and Cyto-VN in SD

punctate28.3306 -
C’ GFP library in SD+DTT

punctate21.580.74Yes -
C’ GFP library in SD+H2O2
punctate29.391.01No -
C’ GFP library in Starvation Media

punctate25.320.87No -
C’ GFP library on the background of Pup2-DaMP

N/A -
C’ GFP library on the background of CCT mutant

N/A0N/AYes
